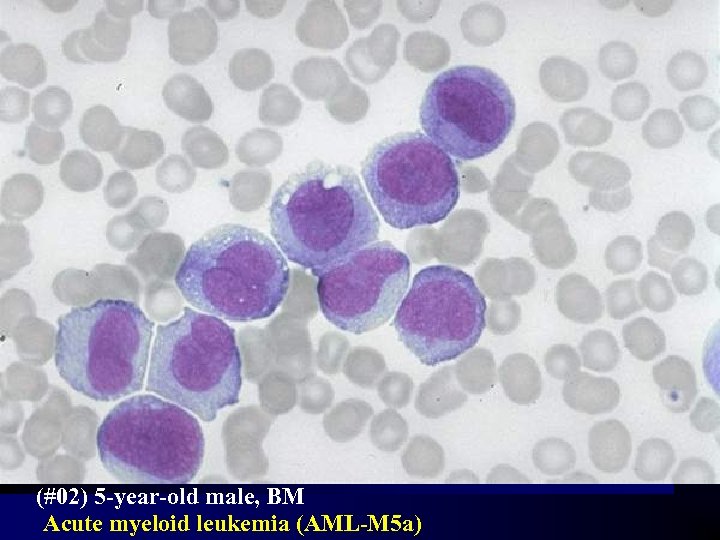
(#02) 5 -year-old male, BM Acute myeloid leukemia (AML-M 5 a)
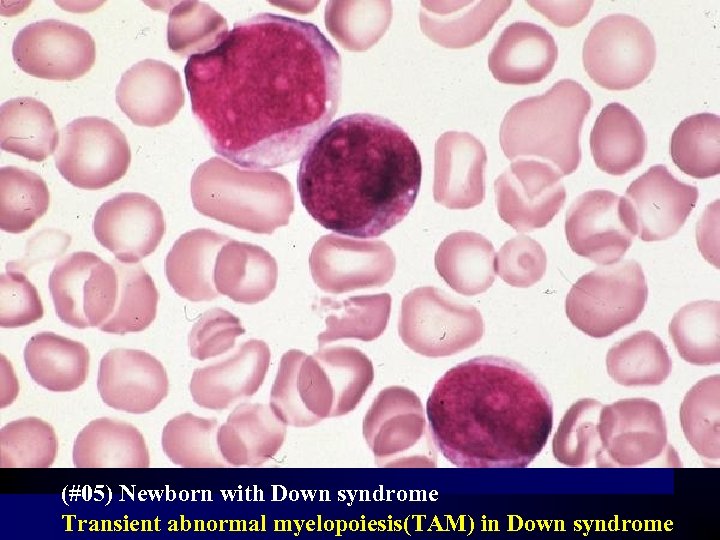
(#05) Newborn with Down syndrome Transient abnormal myelopoiesis(TAM) in Down syndrome
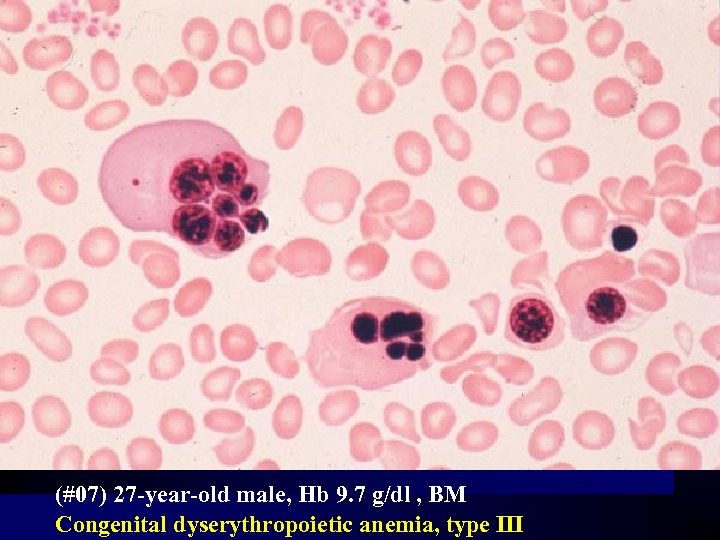
(#07) 27 -year-old male, Hb 9. 7 g/dl , BM Congenital dyserythropoietic anemia, type
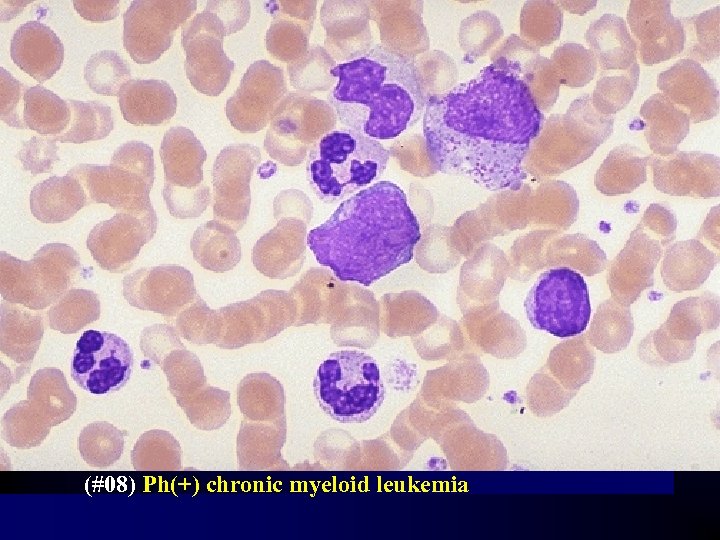
(#08) Ph(+) chronic myeloid leukemia
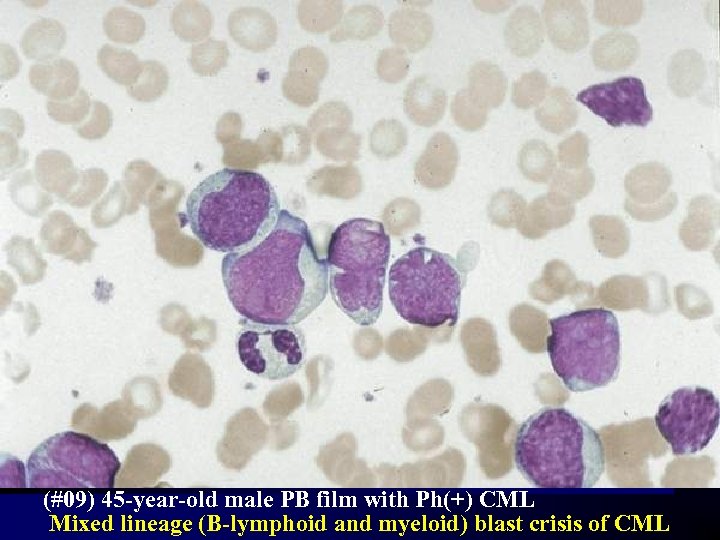
(#09) 45 -year-old male PB film with Ph(+) CML Mixed lineage (B-lymphoid and myeloid)
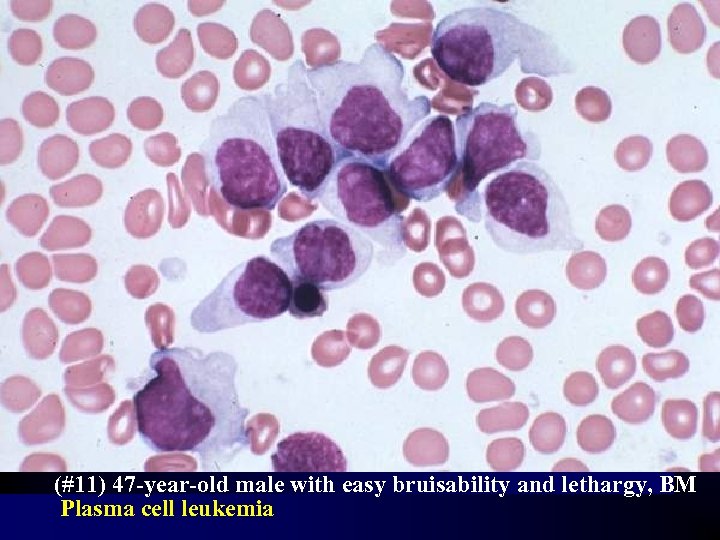
(#11) 47 -year-old male with easy bruisability and lethargy, BM Plasma cell leukemia
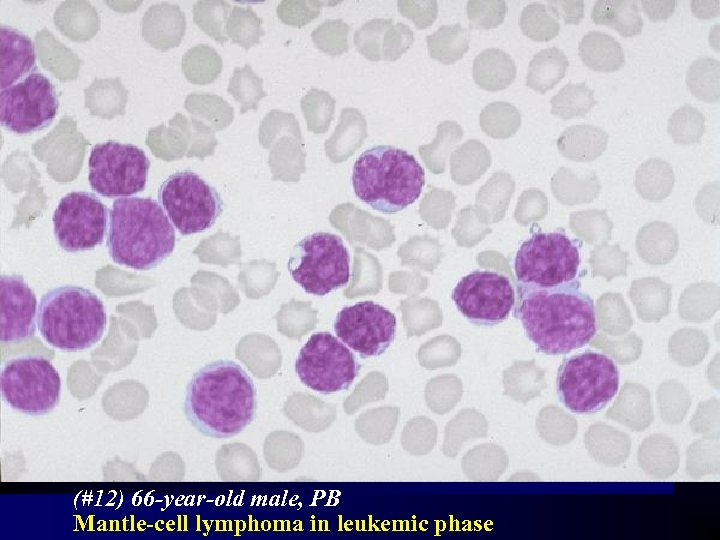
(#12) 66 -year-old male, PB Mantle-cell lymphoma in leukemic phase

833d0277aa5b2b3423950d612048270b.ppt
- Количество слайдов: 36

Morphology Review - ISH Slides 제 2차 혈액학 종합학술대회 발표 2000년 5월 25일-5월 26일 COEX 한림의대 조 현 찬

Clonal Bone Marrow Disorders Lymphoma Metastatic Cancers

FAB Classification n n Standard morphologic classification system Features considered ä Morphology : Cell size, Amount of cytoplasm Nuclear size and shape, Cytoplasmic membrane Cytoplasmic basophilia, Cytoplasmic vacuolations, Other features ä Cytochemistry ä Immunophenotype ä cytogenetic & molecular genetic features ä Other features

M 0 M 7 M 1 M 6 M 5 M 2 M 3 M 4

WHO Classification of Hematologic Malignancies Myeloid Neoplasm n Lymphoid Neoplasm n Mast Cell Disorders n Histiocytic Neoplasm n Diagnistic criteria ä Morphology ä Immunophenotype ä Genetic features ä Clinical syndromes

AML, WHO Classification n n AMLs with recurrent cytogenetic translocations AML with t(8; 21), AML 1/ETO Acute promyelocytic leukemia with t(15; 17) AML with abnormal BM eosinophils with inv(16) AML with 11 q 23 (MLL) abnormalities AML with multilineage dysplasia AML & MDS, therapy-related AML not otherwise categorized AML minimally differentiated AML without maturation AML with maturation Acute myelomonocytic leukemia Acute erythroid leukemia Acute megakaryocytic leukemia Acute basophilic leukemia Acute panmyelosis with myelofibrosis

(# 01) 69 -year-old male Bone marrow film Poorly or minimally differentiated AML (AML-M 0)
(#02) 5 -year-old male, BM Acute myeloid leukemia (AML-M 5 a)

(#03) 67 -year-old woman presented with pancytopenia Acute megakaryoblastic leukemia

(#13) 9 -year-old male with pancytopenia, BM Metastatic rhabdomyosarcoma

Morphology : The tumor cells vary in size; many have irregular cytoplasmic pseudopods. Occasional cells have cytoplasmic vacuoles. n Immunophenotype : CD 41 (Gp. IIb/IIIa) (+) Tentative diagnosis : acute megakaryocytic leukemia was established. n Ultrastructural exam : Rhabdomyosarcoma n
(#05) Newborn with Down syndrome Transient abnormal myelopoiesis(TAM) in Down syndrome

PB ; WBC 88 x 109/L, Hb 14. 2 g/dl and platelets 12 x 109/l. Blast 50 -60% n No phenotyping or chromosome studies. n WBC count gradually returned to normal over 10 weeks. There has been no recurrence and the child is well at nine years of age. n The blasts may express megakaryocytic and/or erythroid markers; promegakaryocytes and micromegakaryocytes may be numerous. n The CBC findings are not helpful in distinguishing the transient disorder from those processes which persist. n

MDS, FAB Classification • Refractory anemia (RA) • RA with ring sideroblasts (RARS) • RA with excess of blasts (RAEB) • RAEB in transformation (RAEB/T) • CMML Other Subtypes MDS with myelofibrosis Hypoplastic MDS Pure sideroblastic anemia

MDS, WHO Classification Refractory anemia with ringed sideroblasts without ringed sideroblasts n Refractory cytopenia(MDS) with multilineage dysplasia n Refractory anemia with excess blasts n 5 q- syndrome n MDS, unclassifiable n

(#04) 37 -year-old female house painter with a history of bruising RAEB-T associated with an isolated 5 q-
(#07) 27 -year-old male, Hb 9. 7 g/dl , BM Congenital dyserythropoietic anemia, type III

Chronic Myeloproliferative Disorders n Chronic myeloid leukemia Atypical CML Juvenile CML Chronic neutrophilic leukemia n n n Polycythemia vera Myeloid metaplasia with myelofibrosis Essential thrombocythemia

MPD, WHO Classification n n n Chronic myelogenous leukemia, Ph(+) (t(9; 22) (q 34; q 11), BCR/ABL) Chronic neutrophilic leukemia Chronic eosinophilic leukemia/hypereosinophilic syndrome Chronic idiopathic myelofibrosis Polycythemia vera Essential thrombocythemia Myeloproliferative disease, unclassifiable Myelodysplastic/myeloproliferative disorders (MD/MPD) CMML, a. CML, JMML
(#08) Ph(+) chronic myeloid leukemia
(#09) 45 -year-old male PB film with Ph(+) CML Mixed lineage (B-lymphoid and myeloid) blast crisis of CML

Lymphoid neoplasm, WHO Classification g B-Cell neoplasm ä ä g Precursor B-cell : ALL Mature(peripheral) B-cell : CLL, HCL, PCM, MCL , Burkitt’s Lymphoma T-cell and NK-cell neoplasm ä Precursor T-cell ä Mature(peripheral) T-cell g Hodgkin’s lymphoma


(#10) 47 -year-old male with an abdominal mass, PB Richter's transformation of B-cell CLL
(#11) 47 -year-old male with easy bruisability and lethargy, BM Plasma cell leukemia

70/F, Sternal pain for 6 years (SNUH) CBC : 8. 5 - 3. 8 - 163 k Total protein/Albumin : 6. 2/3. 3, PEP : no M-spike Plasma cell myeloma with heavy granules

Plasma cell leukemia, PB Multiple myeloma, BM
(#12) 66 -year-old male, PB Mantle-cell lymphoma in leukemic phase

Morphology : medium size lymphoid population having a nucleus with dense but not clumped chromatin, occasional nuclear clefts and a small nucleolus. n Immunophenotype : clonal B-cell population with strong expression of SIg and membrane CD 22(+), CD 5(+), CD 23(-) n Cytogenetic analysis : t(11: 14)(q 13; q 32) n Spleen histology : diffuse involvement by medium size lymphocytes with a cleaved nucleus n

Hairy cell leukemia Middle-aged patients over 50 Weakness and lethargy Splenomegaly (80% ) Hairy cells : Fine & irregular pseudopods, immature nuclear features BM : often unsuccessful

(#14) 52 -year-old male, PB Large-cell lymphoma evolving into leukemia

n Morphology : Large (> 3 times of RBC), reticular chromatin, deeply basophilic cytoplasm and 1 -3 nucleoli. n Immunophenotype : Clonal B-cell population kappa+, lambda-, CD 19+, FMC 7+, and negative with CD 5, CD 23 & CD 2.

(#15) 28 -year-old male, BM ALL-L 3, Burkitt’s lymphoma/Burkitt cell leukemia

(#16) 38 -year-old black Caribbean Peripheral blood Adult T-cell leukemia lymphoma (ATLL).

Morphology : small to medium size lymphocytes with a highly irregular nucleus with inconspicuous nucleolus and multiple indentation n Immunophenotype : mature T-cell (Td. T+, CD 1 a-, CD 2+, CD 3+, CD 5+, CD 7 -) with a CD 4+, CD 8 -, CD 25+ phenotype. n Antibodies to the human T-cell leukemia/lymphoma virus (HTLV-1) n Molecular analysis : a clonal integration of the proviral HTLV-1 in the cell's DNA n

(#17) 2 -year-old boy with mediastinal mass n n CBC : Within normal limits Cell markers : non-B, non-T phenotype Mediastinal mass : plasma cell granuloma. Uneventful recovery from surgery. No follow-up BM study Increased hematogones 50 -55% lymphoid cells with a very high N/C ratio; condensed chromatin, indistinct nucleoli, Some cleft nuclei
833d0277aa5b2b3423950d612048270b.ppt